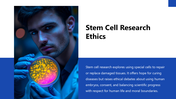
66270-biology-subject-for-high-school-bioethics-08

Informative Biology Subject For High School Bioethics PPT
Biology Subject for High School: Bioethics PowerPoint, Google Slides, and Canva Template
The Biology Subject for High School Bioethics Presentation introduces students to the study of moral and ethical principles guiding biology, medicine, and scientific research. Designed for teachers, educators, and students, this presentation makes complex topics like genetic engineering, stem cell research, and environmental bioethics easy to understand.
This 18-slide presentation is available for PowerPoint, Google Slides, and Canva. Each slide features a clean academic layout with high-quality visuals and clear explanations on key topics such as animal testing ethics, cloning dilemmas, and medical data privacy. It’s perfect for classroom teaching, science fairs, and research discussions.
The presentation helps students explore the balance between scientific innovation and ethical responsibility, encouraging critical thinking and awareness about moral decision-making in science.
Download and use the bioethics presentation today. We’ve designed it to suit your needs, and you can customize it to your preferences with 100% editable slides. Make your biology lessons more engaging, visually rich, and thought-provoking for every student.
Features of this template
- 100% customizable slides and easy to download.
- The slides contain 16:9 and 4:3 formats.
- Easy to change the colors quickly.
- Highly compatible with PowerPoint, Google Slides, and Canva templates.